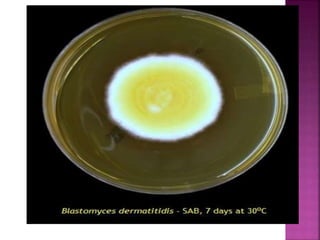

Blastomycosis is a fungal infection caused by Blastomyces dermatitidis that can affect the lungs, skin, and bones. It is contracted by inhaling spores found in soil and is characterized by a pulmonary infection that can disseminate throughout the body. Symptoms vary depending on the infected area but may include cough, fever, and skin lesions. Diagnosis involves culturing samples on agar to demonstrate the fungus's dimorphic nature and ability to convert between mold and yeast forms depending on temperature. Treatment involves antifungal medications such as itraconazole.